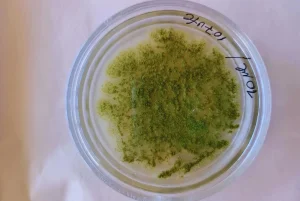

Desarrollan un antihongo natural para proteger a los granos almacenados

Un bioinsumo de origen vegetal para controlar el Aspergillus flavus, que afecta la calidad de los granos y genera micotoxinas peligrosas.
(NAP) Un equipo interdisciplinario de investigadores del Inta —Instituto de Patobiología Veterinaria, Instituto de Suelos e Instituto de Tecnología de Alimentos—, del Instituto de Botánica Darwinion (Conicet/Ancefyn) y de la Facultad de Farmacia y Bioquímica de la UBA trabaja en el desarrollo de un bioinsumo de origen vegetal para controlar Aspergillus flavus, un hongo que afecta la calidad de los granos y genera micotoxinas peligrosas.
(NAP) Un equipo interdisciplinario de investigadores del Inta —Instituto de Patobiología Veterinaria, Instituto de Suelos e Instituto de Tecnología de Alimentos—, del Instituto de Botánica Darwinion (Conicet/Ancefyn) y de la Facultad de Farmacia y Bioquímica de la UBA trabaja en el desarrollo de un bioinsumo de origen vegetal para controlar Aspergillus flavus, un hongo que afecta la calidad de los granos y genera micotoxinas peligrosas.
Este innovador proyecto busca reducir el uso de agroquímicos mediante el aprovechamiento de los compuestos naturales de una especie nativa. El trabajo se enfocó en el desarrollo de un fungicida natural basado en un extracto de Peltophorum dubium, un árbol nativo conocido como Ibirá pitá.
Millones de toneladas de cereales sufren deterioro debido a la acción de hongos que provocan pérdidas de rendimiento y alteraciones en la calidad, generando importantes daños económicos. Entre estos patógenos, Aspergillus flavus se destaca por su capacidad de colonizar granos de cereales y semillas oleaginosas durante el almacenamiento, produciendo aflatoxinas con alta toxicidad para humanos y animales.
“Los hongos son organismos ubicuos con gran capacidad de adaptación. Aspergillus flavus está presente en el ambiente y en la producción agrícola, y en condiciones favorables genera micotoxinas con impacto económico y sanitario”, explicó Lucía Di Ciaccio, investigadora del Instituto de Patobiología Veterinaria del INTA-Conicet.
En este sentido, Renée Fortunato, directora del Instituto Darwinion, destacó que “el hongo persiste desde el campo hasta el almacenamiento, donde si las condiciones no son adecuadas, se generan micotoxinas peligrosas”.
El control de estos hongos se basa en el manejo ambiental y el uso de antifúngicos. Sin embargo, la resistencia fúngica y los efectos adversos de los productos químicos han impulsado la búsqueda de nuevas alternativas.
La investigación identificó que las hojas de Ibirá pitá tienen actividad antifúngica. “Los bioensayos in vitro demostraron que el extracto tiene una acción fungistática, inhibiendo el crecimiento y desarrollo del hongo”, indicó Di Ciaccio, quien detalló que el mecanismo de acción se centra en la pared celular fúngica.
Uno de los hallazgos más prometedores del estudio es que el extracto conserva su eficacia tanto en su hábitat nativo (región chaqueña) como en áreas donde la especie ha sido introducida (región pampeana), aunque con mejor desempeño en su ambiente original. Además, mediante técnicas de microscopía y caracterización fitoquímica, se determinó que los flavonoides son los principales compuestos responsables de la actividad antifúngica.
“El siguiente paso es desarrollar un prototipo transferible al sector agroindustrial, especialmente en el área de postcosecha de granos, donde hay una gran demanda de antifúngicos innovadores”, afirmó Di Ciaccio. Fortunato agregó que este desarrollo también promueve la conservación del recurso genético silvestre y su hábitat, generando un impacto positivo en la biodiversidad y la economía regional.
En definitiva, el extracto de Peltophorum dubium se perfila como una solución sustentable para el control de Aspergillus flavus, con beneficios para la salud humana y animal, el medioambiente y la industria agroalimentaria. Además de su uso directo, podría potenciar la eficacia de antifúngicos sintéticos existentes, abriendo nuevas perspectivas para el manejo integrado de enfermedades en granos almacenados. (Noticias AgroPecuarias)










